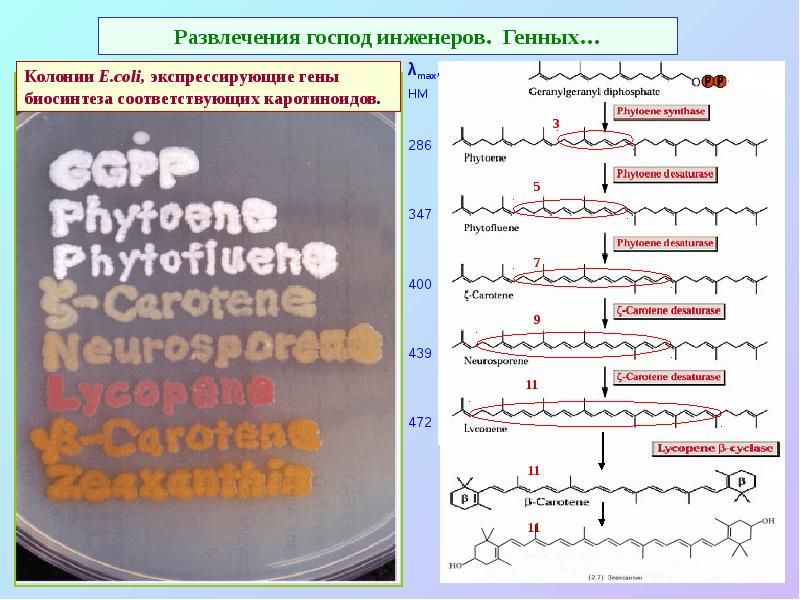
Развлечения господ инженеров. Генных…

Фотосинтез презентация
Содержание
- 3. Хлорофилл: двуликий Янус Red-Ox реакций Хлорофиллов >10: Хл. а, b,
- 4. Многообразие хлорофиллов
- 5. Основные структурные особенности молекулы хлорофилла Конъюгированная система двойных связей: основная 18-членная
- 6. δ-амннолевулиновая кислота – предшественник гема и хлорофиллов.
- 7. Биосинтез порфиринов у растений происходит в пластидах
- 8. Спектры поглощения хлорофиллов
- 9. Энергетические уровни хлорофилла
- 10. Белковое окружение изменяет спектр поглощения хлорофилла
- 11. Первичные процессы фотосинтеза – временные интервалы различаются на 6 -7 порядков
- 12. Простейшая схема фотосинтеза — пурпурные бактерии.
- 13. Вторая простейшая схема фотосинтеза - серные зеленые бактерии.
- 14. Очередная проблема: где взять источник (донор) электронов (окисляемое соединение)? Основные требования
- 15. Как решить проблемы водички в качестве донора электрона? Энергия квантов видимого
- 16. Гениальное решение: соединить две фотосистемы!
- 17. Z-схема: оптимальное сочетание фотосистем позволяет «втиснуть» между ними еще и b6f-комплекс
- 18. Кофакторы ЭТЦ фотосинтеза: знакомые все лица... 2Fe-2S и 4Fe-4S-белки, хиноны (пластохиноны
- 19. Z-схема фотосинтеза
- 20. Z-схема фотосинтеза: RedOx потенциалы компонентов ЭТЦ хлоропластов
- 21. Два типа реакционных центров: феофитин-хиноновый и железо-серный
- 22. Организация фотосинтетического аппарата
- 23. Организация фотосинтетического аппарата весьма похожа на ЭТЦ дыхания
- 24. Организация фотосинтетического аппарата, «реальная картинка».
- 25. Фотосистема II: схема реакционного центра (РЦ) 25 белков: D1 +
- 26. Кинетика работы водоокисляющего комплекса
- 27. Марганцевый кластер системы фотоокисления воды
- 28. Не все так просто и не все так ясно в системе
- 29. Фотосистема II в «реальном виде»
- 30. В6f-комплекс: схема. Два такта работы Q-цикла. Как в митохондриях…
- 31. В6f-комплекс (димер) в «реальном виде»
- 32. Фотосистема I: схема реакционного центра (РЦ) ФСI – 13 белков: А
- 33. Фотосистема I в «реальном виде»
- 34. ЭТЦ хлоропластов: образование NADPH и ATP
- 35. Другие варианты использования электронов с ферредоксина
- 36. Антенны: дополнительные пигменты
- 37. Антенны. Фикобилисомы – светособирающий комплекс цианобактерий и красных водорослей
- 38. Фикобилипротеиды. По набору пигментов в антенных комплексах можно заключить, что симбиоз
- 39. Антенны. Светособирающие комплексы различных организмов
- 40. Каротиноиды: каротины и ксантофиллы – тетратерпены (С40) Различия по концевым группам,
- 41. Развлечения господ инженеров. Генных…
- 42. Схема мономера фотосистемы II с антенными комплексами
- 43. Светособирающий комплекс LHC II (Lhcb 1+2+3) : мономер и тример
- 44. Схема мономера и димера фотосистемы II с антенными комплексами
- 45. Светособирающие комплексы фотосистем I и II
- 46. Состав хлорофилл-белковых комплексов ФСI и ФСII
- 47. Гетерогенность тилакоидых мембран
- 49. Механизмы регулирования и защиты ФСII от фотодеструкции нециклический поток, регулирование мобильными
- 50. Регулирование поглощения света мобильными антеннами
- 51. Варианты электронного транспорта в ЭТЦ хлоропластов
- 52. Варианты электронного транспорта в ЭТЦ хлоропластов, чуть подробнее…
- 53. Циклический поток электронов вокруг фотосистемы II
- 54. Варианты работы ЭТЦ фотосинтеза: Z-схема
- 55. Функции каротиноидов 1. Антенны (400 – 500 нм) 2. Структурная (организация
- 56. Виолоксантиновый цикл – основа «нефотохимического тушения»
- 57. Фотозащита
- 58. D1 белок – «камикадзе» растительной клетки Разборка ФС II: уходят белки
- 59. Темновая фаза фотосинтеза – образование «основных фондов» из НАДФН и АТФ
- 60. Восстановительный пентозо-фосфатный цикл (ВПЦ)
- 61. Скачать презентацию

Слайды и текст этой презентации
Похожие презентации